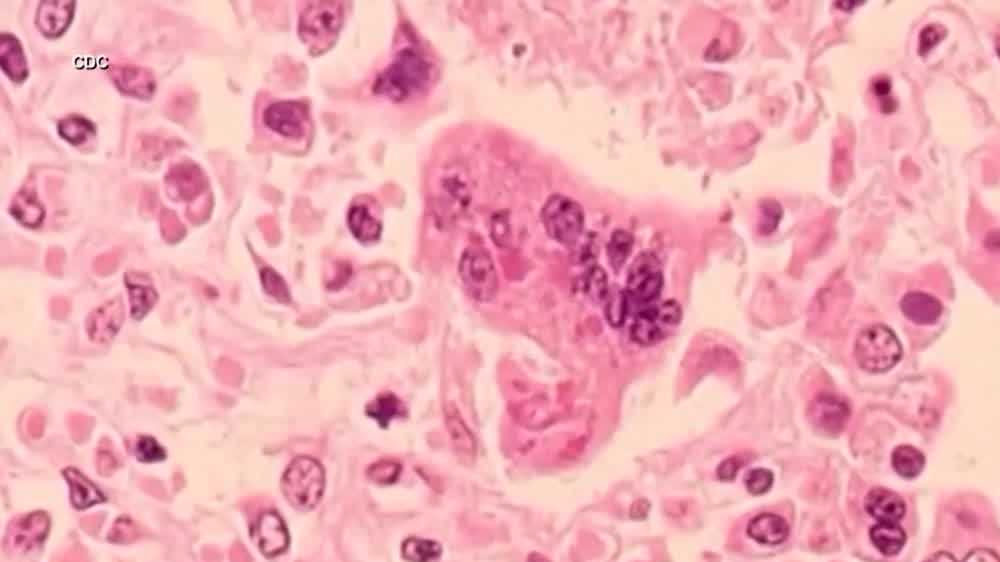

Research Reveals Mpox's Curious Evolution and Global Resurgence Risks
Research shows mpox is evolving with new strains that spread more easily and may affect male fertility, raising concerns about potential future global outbreaks.
All articles tagged with #global outbreak

Research shows mpox is evolving with new strains that spread more easily and may affect male fertility, raising concerns about potential future global outbreaks.

The U.S. has reported its first case of a more aggressive strain of mpox in a traveler from Eastern Africa, confirmed in California. This strain, clade I, is known for causing more severe disease than the clade II strain that spread widely in 2022. While the strain has been spreading in Africa, there is currently no evidence of its spread in the U.S. The CDC is monitoring the situation, and the U.S. has a supply of the Jynneos vaccine to protect high-risk groups. Health officials believe the U.S. is better prepared for an outbreak than in 2022.

A mutant strain of monkeypox with "pandemic potential" has been discovered in the Democratic Republic of Congo, specifically in the town of Kamituga. This new strain, named "clade 1b," is more infectious and better at evading tests than its predecessor, and has already resulted in 108 cases and two deaths. Researchers are calling for urgent measures to contain the virus and prevent a global outbreak, as the highly mobile population of Kamituga, including miners and sex workers, could facilitate its spread. The virus is believed to have emerged in animals and then jumped to humans, particularly affecting sex workers. The international community is urged to roll out vaccines, drugs, and heightened surveillance and contact tracing measures to address the situation.

Whooping cough, a highly contagious respiratory infection caused by Bordetella pertussis, is spreading globally, with outbreaks reported in several countries. The disease, characterized by severe coughing fits and a distinctive "whooping" sound, can be particularly severe in infants and young children. Vaccination, good hygiene practices, and early diagnosis and treatment are key measures to prevent and control the spread of whooping cough, especially among vulnerable populations.
Health officials in New Hampshire are urging vaccination as measles cases rise globally, with concerns over below-average vaccination rates in the state. While the United States has reported 58 cases this year, the largest outbreak is in the United Kingdom. Vaccination rates for measles have fallen in New Hampshire, with kindergarteners below the recommended 95%. Health care providers emphasize the importance of vaccination, as measles is highly contagious and can lead to serious and deadly symptoms for the unvaccinated.

The World Health Organization reported a significant increase in measles cases and deaths worldwide, with 32 countries experiencing large outbreaks in 2022. The decline in vaccination rates has contributed to this surge, with about 61 million doses missed or delayed in 2021. Low-income countries have the lowest vaccination rates, and conflict and disruptions in health services have further impacted vaccination efforts. Urgent and targeted efforts are needed to prevent measles disease and deaths, especially among children under 5 who are at the highest risk for severe complications.

Dengue fever, caused by viruses spread through the bites of infected female mosquitoes, is surging worldwide, with Brazil launching a mass vaccination campaign to control a dramatic uptick in cases. The disease infects an estimated 400 million people annually, with severe cases potentially leading to hospitalization and fatalities. Climate change is allowing the disease-carrying mosquitoes to expand into new areas, posing a global health threat. The US reported 2,556 dengue cases in 2023, and experts warn that climate change could make the country more hospitable to the virus' mosquito vectors. Efforts to develop a vaccine have been complicated by the fact that prior dengue infection can increase the risk of developing severe disease when exposed to a different variant.

A surge of mpox in the Democratic Republic of Congo has raised concerns of another global outbreak, with scientists worried that the world will once again fail to recognize warnings from Africa. Sexual transmission of a more fatal version of the mpox virus has been identified for the first time in a region where mpox is endemic. The World Health Organization has warned that if the situation in Congo is not controlled, it poses a significant risk of international outbreaks with potentially more severe consequences than the one in 2022. The unfolding situation highlights long-standing tensions about how mpox is treated in African countries, renewing questions about health equity and the availability of vaccines.
The Democratic Republic of the Congo is experiencing a significant increase in mpox (monkeypox) cases, with 12,569 suspected cases reported in 2023, the highest ever recorded. The outbreak has expanded to new provinces, including Kinshasa, and has seen the first documented cases of sexual transmission of clade I MPXV, primarily among men who have sex with men. The spread of mpox has been driven by transmission via sexual contact, and the virus has also been detected in other countries outside of Africa. The situation raises concerns about the rapid expansion of the outbreak and the potential for further spread, highlighting the need for enhanced surveillance, testing, and public health measures.

The disease known as monkeypox, renamed mpox, was circulating in humans for over five years before the global outbreak in 2022, according to researchers. The discovery of hidden transmission between humans highlights the need for improved global surveillance to eliminate the virus and prevent future outbreaks. The virus has been evolving due to skirmishes with the human immune system, and it is estimated to have been circulating in humans since at least 2016. While the global outbreak has been declining, other lineages of the virus continue to be reported in countries such as the UK, the US, Portugal, India, and Thailand, suggesting that the epidemic sparked in 2022 is ongoing.

While mpox cases are declining in the United States and Europe, China is experiencing a spike in infections. The country reported 117 cases for the week ending July 21, compared to just six cases throughout all of 2022. Cases have risen by over 50% in the past three weeks. Experts warn that the true extent of the issue may be unknown, as mpox had not been prevalent in China before. The outbreak, which primarily affected gay and bisexual men, began in the UK and spread to Europe and the US. China's irregular case reporting and lack of approved vaccines raise concerns about controlling the spread. Experts emphasize the interconnectedness of the world and the potential for secondary outbreaks in other countries.

The mpox outbreak of 2022, which infected over 87,000 people globally, has ended, but experts warn that the virus has not gone away and the threat of another global outbreak remains. The disease, primarily transmitted through sexual contact, disproportionately affected sexually active gay and bisexual men. Unequal access to vaccines and inadequate surveillance in the Global South have hindered efforts to control the virus. While case counts have declined, experts believe that many cases are going unreported, and there are concerns that global attention to mpox will decline, leaving African countries to deal with the disease on their own. The likelihood of another outbreak is divided among experts, with some warning of a potential future outbreak and others expressing optimism due to widespread immunity and increased awareness.
Sixteen cats in Poland have been confirmed to be infected with the H5N1 subtype of avian influenza, as reports of mammals being infected with the virus continue to rise globally. The infected cats were found in various locations across the country, and the source of infection has not yet been identified. Mass die-offs of seals, sea lions, foxes, skunks, dolphins, raccoons, cats, ferrets, and other mammals have been reported in Russia and the Americas. The outbreak of avian influenza has also affected dogs, cats, and other pets in multiple countries. The European Centre for Disease Prevention and Control (ECDC) has proposed new instructions for strengthening hospital surveillance for severe human bird flu infections.